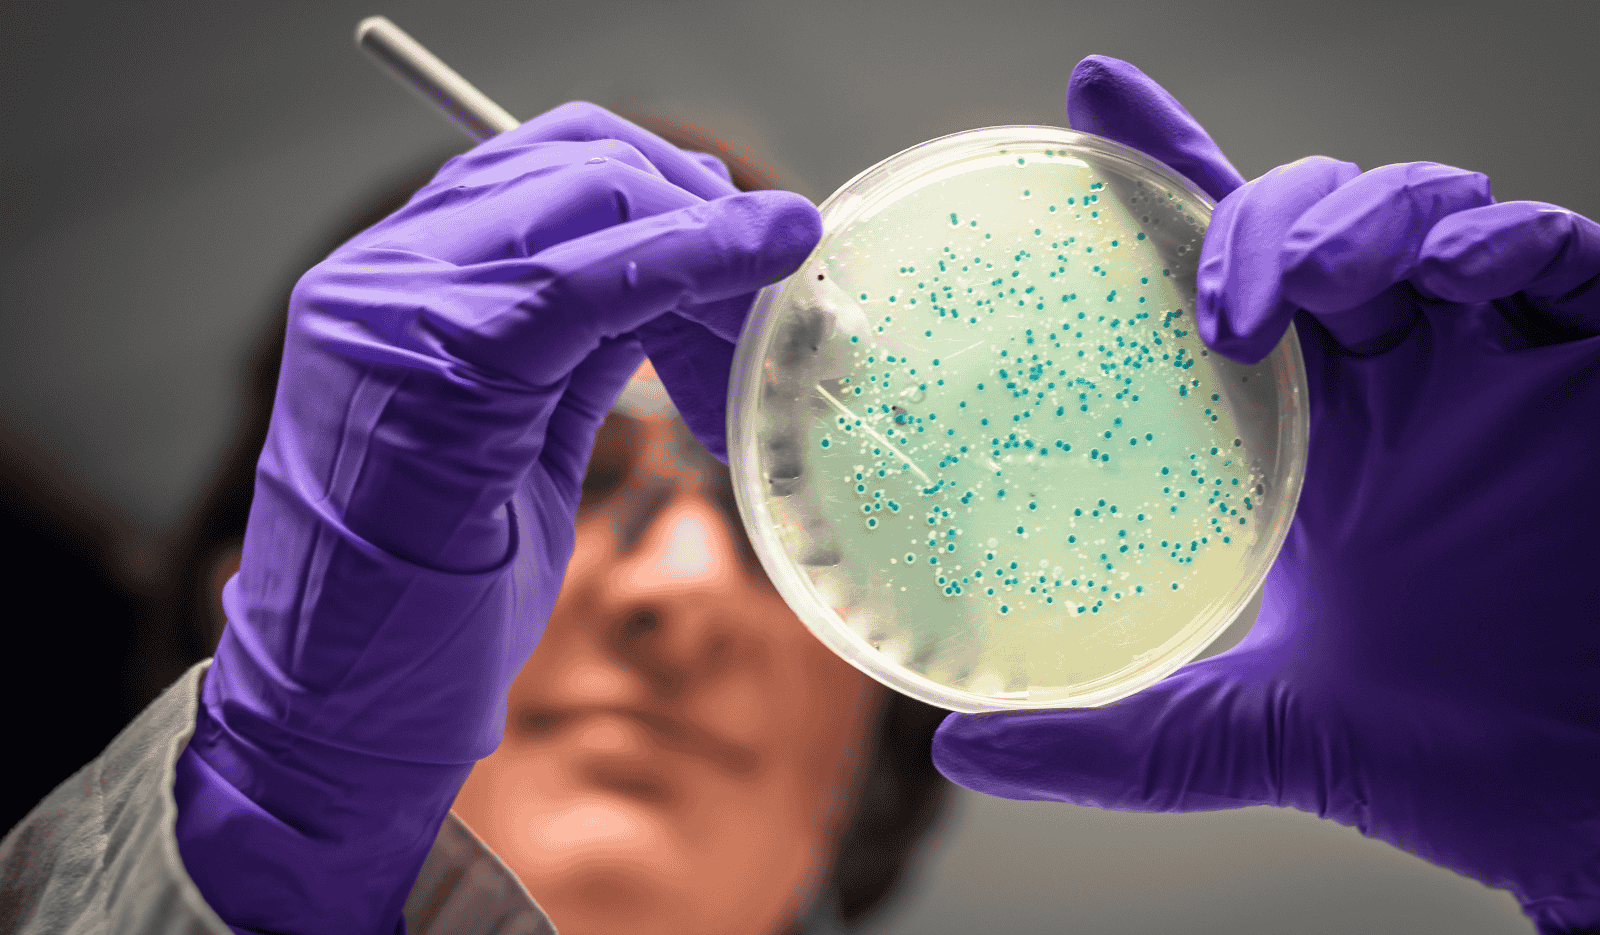
Microbial Disinfection Treatment For Coronavirus

The unprecedented pandemic Corona Virus has caused havoc all across the globe. There has been huge loss to lives and more people have got infected with the disease. Even after vaccination drive, people cannot let their guards down and have to be vigil and follow the Covid protocols to the core.
TThe outbreak of Covid-19 calls for disinfecting of homes to keep yourself and your family safe and healthy. While person to person transmission of the virus posses a much greater risk than transmission via surfaces, it is equally important to clean and disinfect high-touch surfaces of your home.
We follow strict safety procedures even to clean. The team members wear protective clothing, gloves, and facemask and carry out extensive testing until they are satisfied that the mold problem is completely removed. Helping repair mold damage, contain any damp patches, and restore the affected area to its original condition are other services we offer as part of the cleanup process

At Rajdhani Pest Control, our team consists of highly trained professionals with extensive expertise in pest control solutions. Each member is committed to delivering top-notch service, ensuring your home and workplace remain pest-free. We use industry-approved methods, advanced equipment, and eco-friendly solutions to provide safe and effective results.
A pest-free home is a healthy and happy home. At Rajdhani Pest Control, we ensure that your living space remains safe, hygienic, and visually appealing by eliminating pests and preventing future infestations. Our team works efficiently to maintain cleanliness, protect your home’s aesthetics, and enhance overall well-being. Whether it’s insect control, rodent management, or deep sanitation, we are committed to making your home look and feel its best.
Copyright © 2024, Rajdhani Pest Control All Right Reserved Digicircal